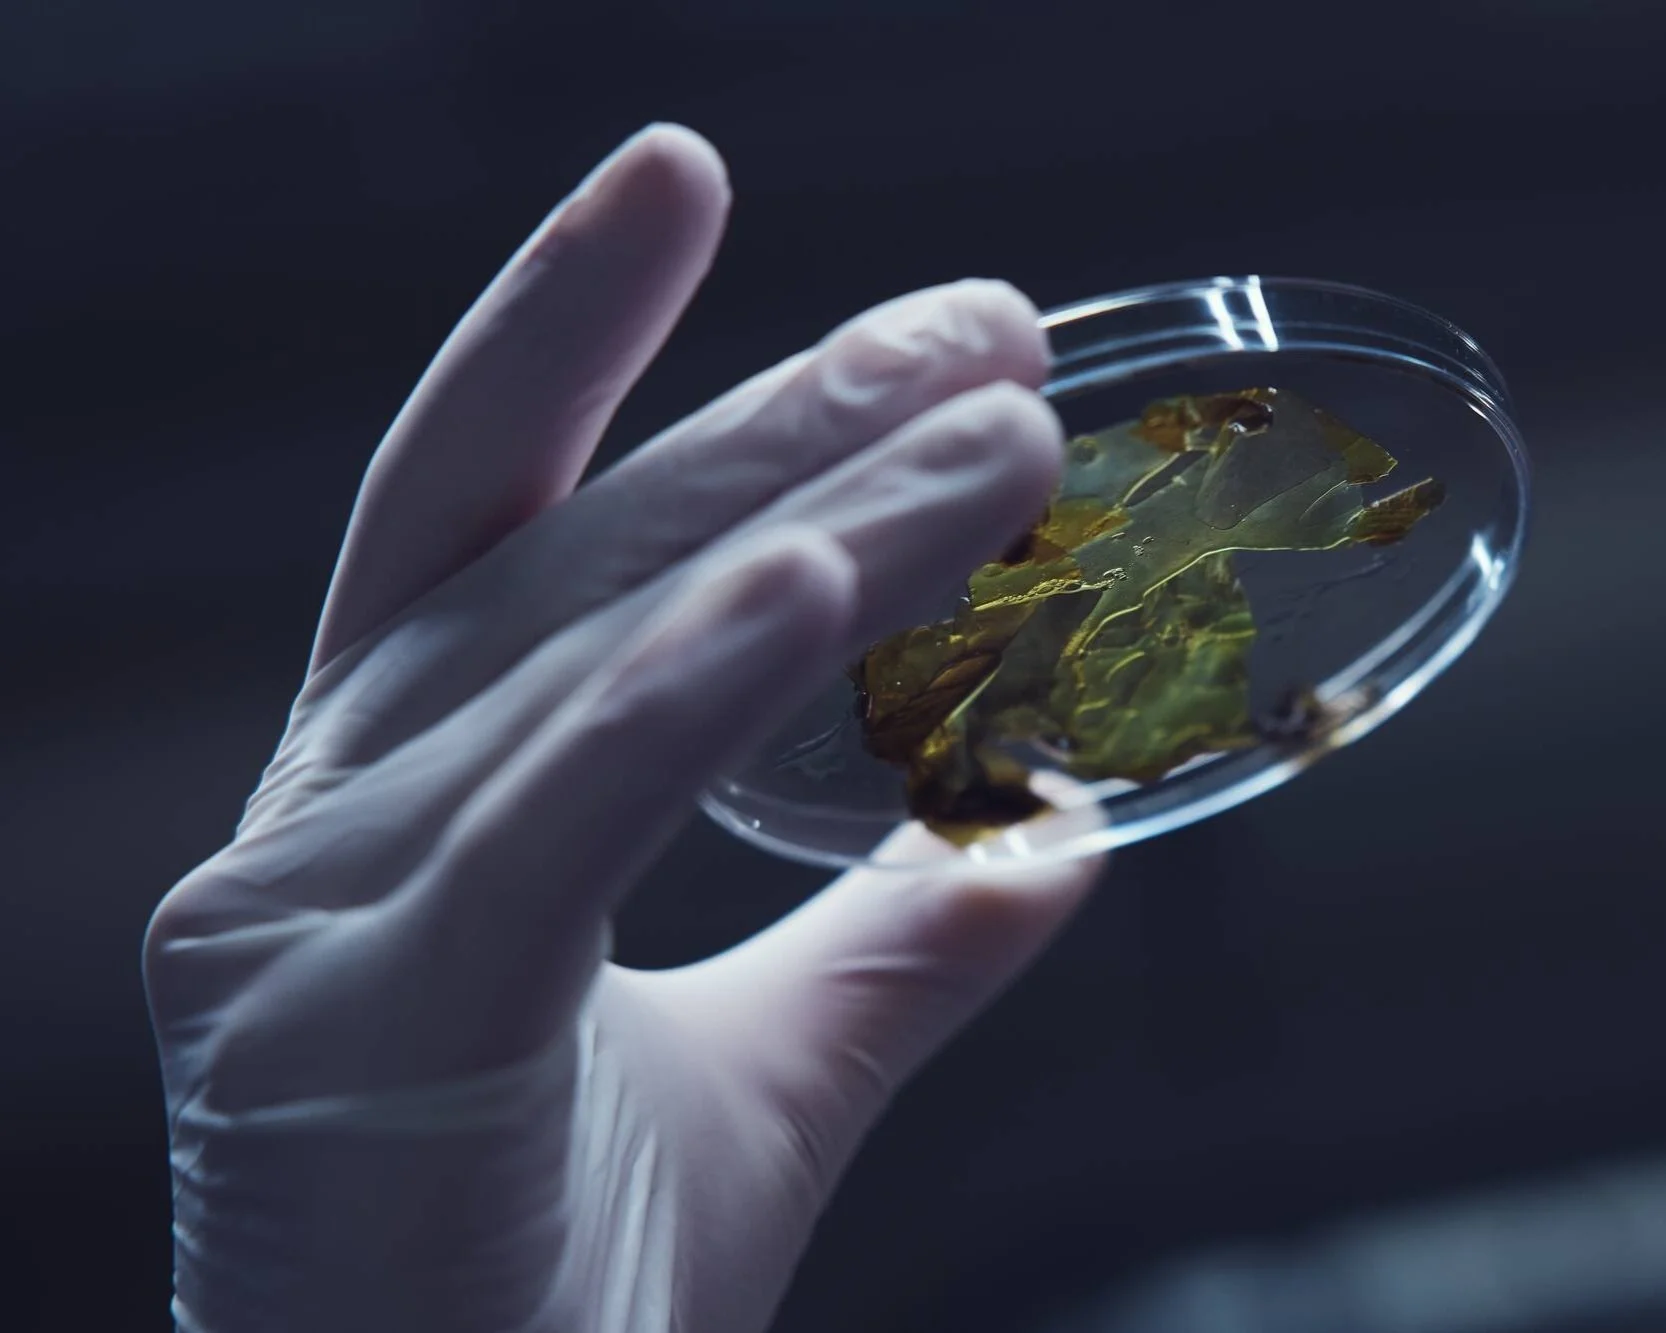

Centralt i Göteborg, plats bekräftas inom kort.
Nätverkande.
Centralt i Göteborg, plats bekräftas inom kort.
SEB bjuder in till en inspirerande entreprenörslunch med fokus på SEB Innovation Forum och möjligheterna att nätverka.
Under SEB Innovation Forum möts innovativa företag som pitchar sina idéer och investerare som är redo att bidra med både kapital och expertis. Genom att sammanföra nya idéer med erfarna investerare skapar vi en plattform för framtidens tillväxtföretag och främjar innovation och utveckling.
Organizer: SEB
Entreprenörslunch
Investor Screening:
Are You Aware of Your Responsibilities Under the FDI Act?
28 Januari, 11:30 - 13:30
Welcome to our event, held in collaboration with Mannheimer Swartling. In December 2023, the FDI Act introduced strict reporting requirements for investments in "Protected Activities." Join us to learn about this important legislation and how to navigate its regulations effectively.
Organizer: FinansKompetensCentrum

28 Januari, 11:30 - 13:30

